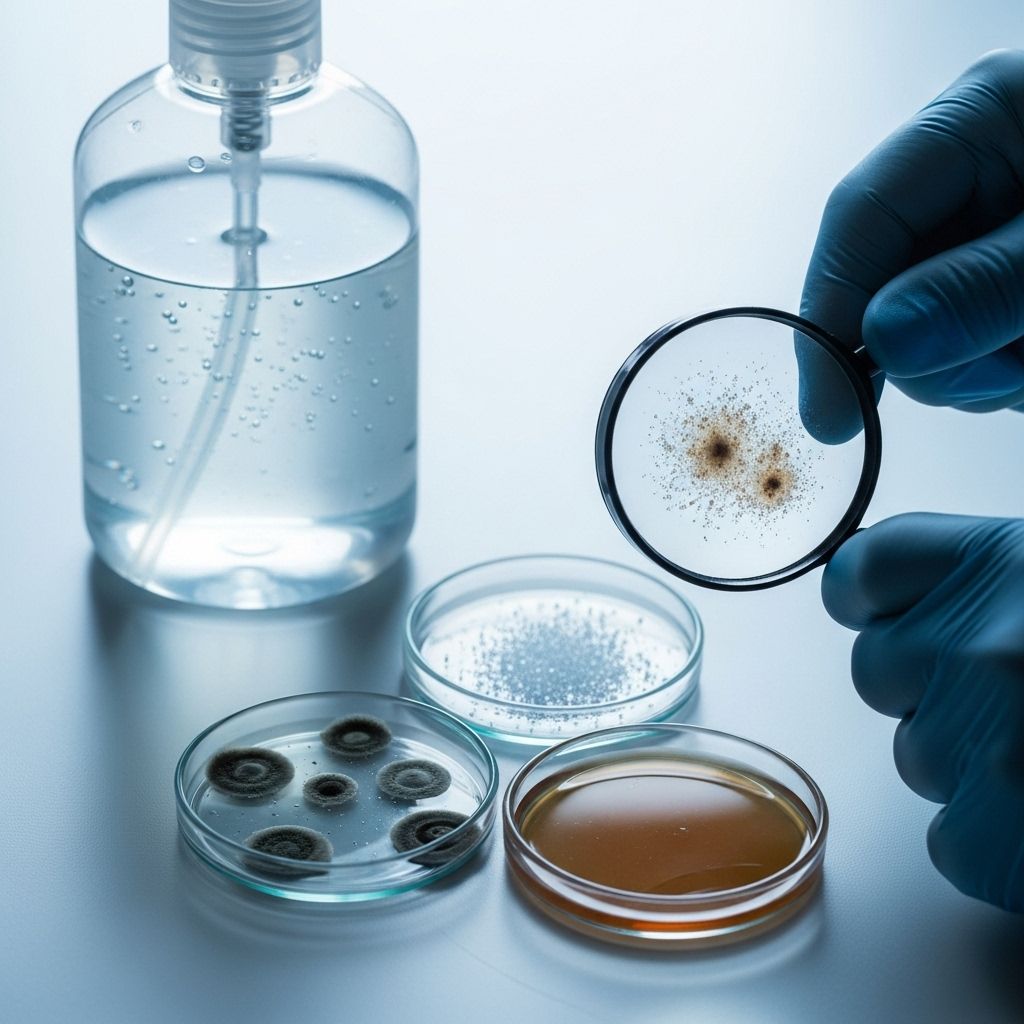

FDA Hand Sanitizer Recalls: Toxic Methanol and COVID-19 Safety Concerns
Effective hand hygiene hinges on knowing which products to trust and which to avoid.
FDA Expands Hand Sanitizer Recall Amid COVID-19 Fears
In response to the COVID-19 pandemic’s surge in demand for hand sanitizers, the U.S. Food and Drug Administration (FDA) has issued a recall encompassing more than 149 different hand sanitizing products. This unprecedented action comes after randomized tests detected the presence of methanol, a toxic alcohol, and other hazardous contaminants in numerous sanitizer brands. Concerns have also grown about certain products being ineffective due to insufficient alcohol content, raising public health alarms across the United States.
Why Were Hand Sanitizers Recalled?
The FDA initiated the recall mainly for two reasons:
- Methanol Contamination: Many recalled products tested positive for methanol (wood alcohol), a substance highly toxic when ingested or absorbed through the skin.
- Ineffective Sanitizers: Some sanitizers lacked the minimum required alcohol concentration, rendering them ineffective against viruses like SARS-CoV-2, the cause of COVID-19.
Additionally, a subset of products contained 1-propanol, another toxic alcohol linked to adverse central nervous system effects.
Summary Table: Key Hazards Identified
| Identified Hazard | Description | Potential Health Effects |
|---|---|---|
| Methanol | Toxic alcohol, not approved for sanitizer use | Blindness, seizures, hospitalizations, death |
| 1-Propanol | Another toxic alcohol | Respiratory depression, CNS effects, possible death |
| Insufficient Alcohol | Lacks 60% ethanol or 70% isopropanol | Ineffective protection against viruses, false sense of safety |
What is Methanol and Why Is It Dangerous?
Methanol, also known as wood alcohol, is a colorless, volatile liquid used industrially as a solvent, antifreeze, or fuel. It is not an acceptable ingredient in hand sanitizers and can be hazardous if absorbed through the skin or, more severely, if ingested.
- Health effects of methanol exposure include:
- Nausea and vomiting
- Headache
- Blurred vision or permanent blindness
- Seizures, coma
- Permanent nervous system damage or death
The FDA has directly linked the ingestion of methanol-contaminated hand sanitizers to recent cases of blindness, hospitalizations, and fatalities in both adults and children.
Which Hand Sanitizers Were Recalled?
The FDA recall list contains over 149 unique hand sanitizer products, many of which were manufactured in Mexico or distributed by companies based there. This list has expanded continuously as further products fail random safety tests. The FDA maintains an online database of these products, which the public should refer to before purchasing or using any sanitizer during the pandemic.
Common Traits of Recalled Products
- Often labeled as “Made in Mexico”
- Commonly sold in convenient places, such as supermarkets and department stores
- May appear indistinguishable from genuine, safe hand sanitizers in terms of packaging
How Were These Products Discovered?
Growing reliance on hand sanitizer during the pandemic triggered a spike in production and sales, sometimes stretching beyond established supply chains. The FDA responded with regular, randomized testing of products. Samples that failed — either due to toxic contamination or insufficient alcohol content — prompted recalls and consumer advisories.
Due to the unprecedented demand for sanitizer in early 2020, many consumers found store shelves empty, fueling purchases from less familiar brands, some of which turned out to be unsafe.
The FDA’s Official Safety Warnings
The FDA’s warning is unambiguous:
“The agency is aware of adults and children ingesting hand sanitizer products contaminated with methanol that has led to recent adverse events including blindness, hospitalizations, and death. Methanol is not an acceptable active ingredient for hand sanitizers and must not be used due to its toxic effects.”
Furthermore, certain hand sanitizers have been flagged for having insufficient alcohol, thus offering no protection against COVID-19, and others for containing 1-propanol, which is similarly hazardous to humans.
Alternatives: The Best Ways to Clean Hands and Reduce Risk
Hand sanitizer offers a quick solution when soap and water are unavailable, especially in public spaces. However, proper technique and ingredient awareness are crucial. The Centers for Disease Control and Prevention (CDC) still recommends washing with soap and water as the most effective defense against viruses and bacteria.
CDC Hand Hygiene Recommendations
- Wash your hands with soap and water for at least 20 seconds.
- Use hand sanitizer only when soap and water are not accessible.
- Ensure sanitizers are alcohol-based, containing at least 60% ethanol or 70% isopropanol, to effectively kill germs.
- Avoid any product with methanol or insufficient active alcohol content.
- Never ingest hand sanitizers; keep them out of children’s reach.
Recognizing Unsafe Products: Consumer Instructions
Consumers should be vigilant and:
- Check the FDA hand sanitizer recall list regularly before buying or using products.
- Dispose of any recalled sanitizer following local hazardous waste disposal guidelines.
- Be cautious of new or unfamiliar brands, especially those labeled as imported during the pandemic supply crunch.
- Read ingredient labels carefully, ensuring the product does not contain methanol and meets CDC alcohol percentage guidelines.
International Recalls, Labeling, and False Claims
This issue is not confined to the United States. Other regulatory bodies, such as Health Canada, have issued their own recalls and advisories, related to:
- Contaminated ingredients (especially methanol and other industrial-grade alcohols)
- Packaging that mimics safe products
- Misleading claims about sanitizer effectiveness during the pandemic
Products marketed with false assurances or improper labeling may leave users vulnerable to infection or even cause direct harm if contaminated ingredients are present.
Key Takeaways for Consumers
- Methanol poisoning is a serious risk with recalled hand sanitizers, potentially causing lasting injury or death.
- Not all hand sanitizers provide the expected protection; check for CDC-recommended alcohol percentages and FDA safety information before use.
- When in doubt, choose handwashing as the preferred hygiene method.
Frequently Asked Questions (FAQs)
How can I find out if my hand sanitizer is recalled?
Visit the FDA’s official hand sanitizer recall list online and search your product’s name, manufacturer, or National Drug Code (NDC) before use.
What should I do if I have a recalled hand sanitizer?
Immediately stop using the product. Dispose of it as hazardous waste if advised by local authorities. Do not pour it down the drain or flush it down the toilet, as methanol may contaminate water systems.
Can methanol be absorbed through skin contact?
Yes. Frequent application of methanol-contaminated products can result in toxic exposure, not just from ingestion but skin absorption as well. Children are especially vulnerable.
Is all hand sanitizer dangerous?
No. Hand sanitizers free from contaminants and meeting alcohol content guidelines are effective and safe for public use. Stick to brands listed as safe by the FDA and CDC.
What are the symptoms of methanol poisoning?
Early signs include headache, dizziness, nausea, and vomiting. In severe cases, it can cause vision problems, seizures, coma, or death. Seek immediate medical help if exposure is suspected.
Hand Sanitizer Safety: What to Remember During a Pandemic
- Check product recalls before purchase and use.
- Supervise children when using any sanitizer.
- Choose soap and water as your first defense against germs whenever possible.
- Report any adverse health effects or product issues to the FDA’s MedWatch program.
References to Regulatory Guidance and New Developments
The FDA updates its recall list as new information and test results emerge. Public health authorities also stress the continued importance of consumer awareness in making safe hygiene choices, particularly as the pandemic drives new, untested products into the marketplace.
External Resources
- FDA Hand Sanitizer Recall List
- CDC Hand Hygiene Recommendations
- Health Canada Hand Sanitizer Recalls
Final Thoughts
The FDA’s recall of over 149 hand sanitizers is both a warning and a vital teaching moment for American consumers. Safe hygiene is essential during pandemics, but so is vigilance concerning the products we trust. By staying informed, checking official resources, and prioritizing proper handwashing, individuals can protect themselves and their families from both infection and the unintended hazards of substandard sanitizing products.
References
- https://www.foxbusiness.com/lifestyle/fda-recalls-hand-sanitizer
- https://www.cbsnews.com/news/sanitizer-fda-warning-covid-19-protection/
- https://ncceh.ca/resources/blog/hand-sanitizer-contamination-prompts-more-recalls-during-covid-19
- https://www.goodhousekeeping.com/health/a33217666/fda-recalls-hand-sanitizers-coronavirus/
- https://www.goodhousekeeping.com/health/a66042042/dermarite-soap-hand-sanitizer-recall/
- https://www.fda.gov/drugs/drug-safety-and-availability/fda-updates-hand-sanitizers-consumers-should-not-use
- https://www.fda.gov/drugs/drug-safety-and-availability/qa-industry-withdrawal-temporary-hand-sanitizer-guidances
Read full bio of Sneha Tete












